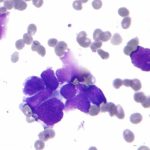

В Ташкенте пресекли продажу царских монет, извещает Генеральная прокуратура Узбекистана.

В Ташкенте пресекли продажу царских монет, извещает Генеральная прокуратура Узбекистана.

По оценкам экологов, новый комплекс «Истиклол» будет стоить ташкентскому парку «Голубые купола» пятисот деревьев. Их спилят.

На посту Рохат при въезде в Ташкент на ровном месте перевернулся джип Toyota Land Cruiser и чуть не сбил сотрудников ГАИ. Дебилизм редкий!

В Музыкальной гостиной Государственного академического Большого театра оперы и балета ГАБТ им. А. Навои на вечер романсов русских композиторов собралось необычно много любителей…

Экологи России обнаружили электромагнитное излучение, исходящее от простого роутера.

Внезапный перенос президентских выборов в Узбекистане вызвал волну комментариев.

Посольство США в Туркмении потеряло новое здание-его до основания снесли, пишет turkmen.news.
В Каттакургане задержан 40-летний организатор петушиных боев, извещает самаркандское телевидение.

Трагически закончился выезд Cobalt на встречку в Язъяване, извещает пресс-служба Ферганского Управления внутренних дел.

Анастасия Вертинская сегодня жалеет о разводе с Никитой Михалковым. За него она вышла, когда будущей знаменитости было всего 20 лет. У звездной пары…

Польша, Швеция и Германия заявили о высылке российских дипломатов. Таким образом эти государства ответили на решение Министерства иностранных дел России объявить персонами нон…

Сына бывшего премьер-министра Таджикистана Иззатулло Хаёева – главу корпорации «ХИМА» и компании «ХИМА Текстиль» Исматулло Хаёева – приговорили в Душанбе к 8 годам…

Новые треволнения ждут ташкентцев в ближайшем будущем, предупредил заместитель хокима узбекской столицы Бахтиёр Рахмонов.

Российская общественность требует вернуть на Лубянскую площадь памятник Дзержинскому. Он был убран в 1991-ом еще при Борисе Ельцине, известил писатель Игорь Молотов.

В Государственном театре музыкальной комедии Узбекистана рискнули (после Гайдая!) по-своему поставить спектакль по пьесе Михаила Булгакова «Иван Васильевич».

В Нидерландах после прививки американской вакциной Pfizer (при участии немецкого стартапа BioNTech) скончались стариков старше 70 лет, извещает NL Times.
В Бухаре ВИЧ-инфицированный 26-летний мужчина специально заражал женщин. Хотя был предупрежден об уголовной ответственности.